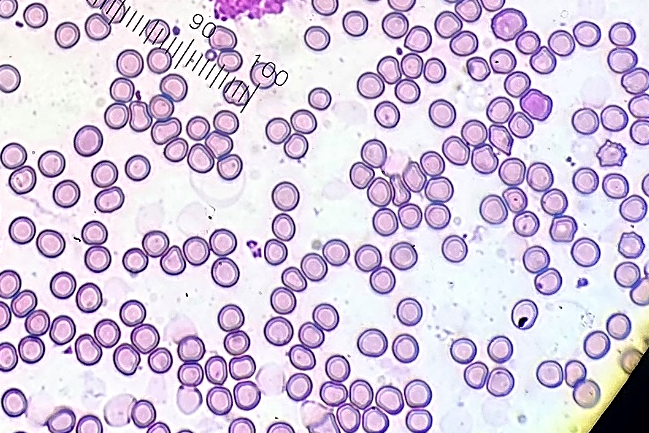
哺乳類赤血球写真.png
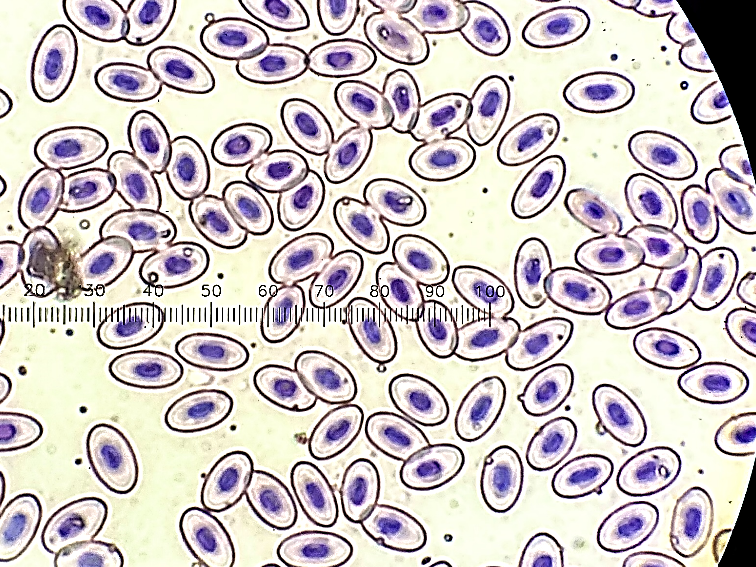
鳥類赤血球写真.png

更新日:2023.03.19みんなちがってみんないい
みんなちがってみんないい
突然ですが、みなさんの胃袋は何個ありますか?
一つに決まってるでしょ!!と突っ込みたくなると思います。
人間はもちろん一つです。
ですが当たり前だと思っている臓器の数も、実は動物種によっては人間と異なります。
ウシやシカ、またキリンなどの反芻動物ではなんと胃袋が4つあり、
効率よく植物を消化、エネルギーにするためにそれぞれの部位が異なる働きをしています。
身近に観察できる場所といえば、焼肉屋さんです。
ミノ・ハチノス・センマイ・ギアラと呼ばれている部位のお肉は、
実はそれぞれウシの第1胃~4胃なのです。
イタリア料理でも、第2胃はトリッパというお料理で有名です。
色々話がずれてきましたが、これらの部位をよくよく観察してみると、
同じ胃なのにそれぞれ見た目が大きく異なることが分かります。
他にも鳥類では胃は、前胃、筋胃の2つに分かれており、それぞれ異なる働きをしています。
焼き鳥屋さんなどでは筋胃は砂肝と呼ばれてます。
また鳥の種類によっては食道の一部が変化した「そ嚢」といった私たちにはない、
食べ物を一時的に蓄えておくための器官があります。
こちらはニワトリのレントゲン写真です。白く造影されているのが「そ嚢」です。
では...動物に共通して赤い血液は、どうでしょうか???
実際に見てみましょう。
こちらは哺乳類の赤血球の顕微鏡写真です。
のっぺりとした形であることが分かると思います。
哺乳類の赤血球は、真ん中がへこんだおはじきのような形状をしています。
では鳥類の赤血球はどうでしょうか。
哺乳類とは異なり赤血球が大きく細長く、また中に濃く染まっている「核」というものがあるのが分かります。
最後にこちらは爬虫類の赤血球です。

こちらの赤血球の中にも「核」がありますが、ころんとしていて鳥類とはまた違った形なのが分かると思います。
このように、レントゲンで写る臓器や血液検査だけでも動物種によって大きく異なり、
獣医師としては面白くもあり大変でもあります。
また他にもご紹介できればと思います。
花粉症がつらい 病院班 真砂